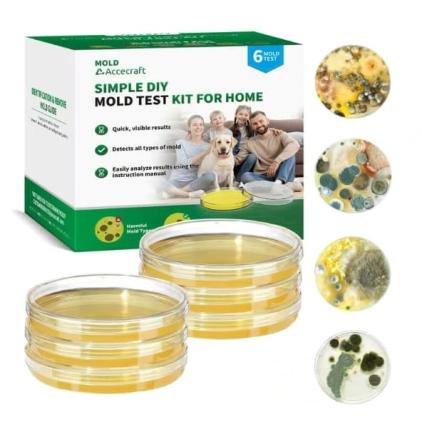

| Sale Limit | Rem. Orders | Product Name | Market | Product ID | Image |
|---|---|---|---|---|---|
| 3 | 3 | https://amzn.to/49B8eJz | UK | 1122240 |

|
| 3 | 2 | https://amzn.to/49xcZnq | DE | 1122226 |

|
| 3 | 3 | https://amzn.to/4o6MRTW | USA | 1122222 |

|
| 3 | 3 | https://amzn.to/3LStQqQ | USA | 1122220 |

|
| 2 | 2 | https://amzn.to/4827gF3 | USA | 1122216 |

|
| 2 | 2 | https://amzn.to/4r5Be29 | USA | 1122215 |

|
| 1 | 1 | peniscreme | DE | 1122213 |

|
| 2 | 2 | https://amzn.to/4odNmLX | USA | 1122212 |

|
| 1 | 1 | 3-in-1 soil moisture meter | USA | 1122205 |

|
| 2 | 2 | cat repellent | UK | 1122204 |

|
| 2 | 2 | cat repellent | UK | 1122203 |

|
| 2 | 2 | anti snoring devices mouth guard | UK | 1122200 |

|
| 2 | 2 | anti snore mouth guard | UK | 1122199 |

|
| 2 | 2 | EMWEYKE 2 Packs USB C Headphones for iPhone | UK | 1122197 |

|
| 2 | 2 | Caricatore per Apple Watch | IT | 1122196 |

|
| 2 | 2 | chargeur watch apple | FR | 1122194 |

|
| -8 | -8 | air mattress patch kit | USA | 1122193 |

|
| 2 | 2 | mold test kit for home | USA | 1122192 |
|
| 2 | 2 | Use Link 🖇️ | USA | 1122190 |

|
| 2 | 2 | zevo flying insect trap refill | USA | 1122189 |

|
| 2 | 2 | starlink mini cable usb c | USA | 1122188 |

|
| 2 | 2 | starlink gen 3 cable | USA | 1122185 |

|
| 2 | 2 | starlink gen 3 mount | USA | 1122175 |

|
| 2 | 2 | https://amzn.to/4iku3PS | USA | 1122172 |

|
| 2 | 2 | starlink mini suction cup mount | USA | 1122170 |

|
| 2 | 2 | Heated Water Bowl for Dog Cat | USA | 1122164 |

|
| 2 | 2 | flea collar for dogs | USA | 1122155 |

|
| 2 | 2 | use Link 🔗 | USA | 1122153 |

|
| 2 | 2 | Electric Nasal Aspirator Baby | UK | 1122146 |

|
| 2 | 2 | Use safe Link 🖇️ | UK | 1122143 |

|
| 1 | 1 | Indoor TV Aerial | UK | 1122133 |

|
| 2 | 2 | GPS Tracker | USA | 1122116 |

|
| 1 | 1 | rubber cement | USA | 1122105 |

|
| 2 | 1 | https://amzn.to/47Sq8WT | UK | 1122095 |

|
| 1 | 1 | bed rails for elderly adults safety | USA | 1122093 |

|
| 2 | 2 | adventskalender füllung | USA | 1122086 |

|
| 2 | 2 | indoor camera | USA | 1122085 |

|
| 2 | 2 | travel pillow | USA | 1122065 |

|
| 2 | 2 | Marderschreck Auto | USA | 1122064 |

|
| 2 | 2 | travel pillow | USA | 1122050 |

|
| 2 | 2 | walkers for seniors | USA | 1122047 |

|
| 2 | 2 | travel pillow | USA | 1122041 |

|
| 2 | 2 | Whiskey Smoker Kit | USA | 1122037 |

|
| 2 | 2 | travel pillow | USA | 1122034 |

|
| 2 | 2 | Serum For face M88 | USA | 1122020 |

|
| 2 | 2 | https://amzn.to/49AHg4N | IT | 1122018 |

|
| 2 | 2 | https://amzn.to/49qSrwL | IT | 1122010 |

|
| 2 | 2 | propane heater | USA | 1122006 |

|
| 2 | 2 | Retinol Eye Stick | USA | 1122005 |

|
| 2 | 2 | lumiboard led drawing board | USA | 1121940 |

|